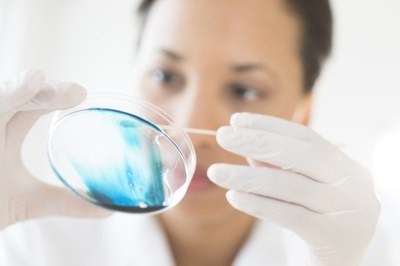

Het project ‘TARGETED BIOMARKER DEVELOPMENT FOR AMYOTROPHIC LATERAL SCLEROSIS’ werd geselecteerd voor het Fonds voor Translationeel Biomedisch Onderzoek. Het project ontwikkelt mechanisme-gebaseerde biomarkers voor ALS.
Over het Fonds voor Translationeel Biomedisch Onderzoek
De Groep Biomedische Wetenschappen creëerde een Fonds voor Translationeel Biomedisch Onderzoek (FTBO). Het fonds voorziet elk jaar een krediet om clinici en basisonderzoekers te ondersteunen, zodat ze de klinische toepassingen van bevindingen uit het basisonderzoek verder kunnen bestuderen. Een adviesraad onder leiding van de onderzoekscoördinator van de Groep Biomedische Wetenschappen beoordeelde de ingediende projecten.
Eén project uitgekozen
Op advies van de raad selecteerde het Groepsbestuur één project dat drie jaar lang een budget van 80.000 euro – in totaal dus 240.000 euro – krijgt toegekend: ‘TARGETED BIOMARKER DEVELOPMENT FOR AMYOTROPHIC LATERAL SCLEROSIS’. De promotoren zijn professoren Sandrine Da Cruz, Koen Poesen, Philip Van Damme en Ludo Van Den Bosch.
Gerichte biomarkerontwikkeling voor ALS
Amyotrofische lateraalsclerose (ALS) is een ernstige en snel voortschrijdende ziekte waarbij de motorische zenuwcellen langzaam afsterven. Ondanks veel vooruitgang in onderzoek is er nog steeds een groot gebrek aan goede biomarkers. Dat zijn meetbare stoffen die kunnen aangeven wat er precies misgaat in het lichaam.
De biomarkers die we vandaag gebruiken, zoals neurofilamenten, tonen wel aan dat zenuwcellen beschadigd zijn, maar ze vertellen niet welke processen in de cellen fout lopen. Daardoor wordt het moeilijker om behandelingen te ontwikkelen die precies op het juiste mechanisme ingrijpen.

Ruimtelijke transcriptomics van menselijke ruggenmergmonsters identificeert alle verwachte celtypes van het centrale zenuwstelsel op basis van genexpressieprofielen van 266 genen. Elke stip stelt één enkele cel voor. De stalen omvatten zowel pathologisch normale donoren als personen met ALS.
Wat wil dit project doen?
Het project heeft als doel nieuwe biomarkers te ontdekken die beter weergeven welke ziektemechanismen actief zijn bij ALS. Om dit te realiseren maken onderzoekers gebruik van verschillende soorten gegevens. Ze werken met stamcelmodellen (iPSC’s) die menselijke zenuwcellen nabootsen, met transgene muizenmodellen waarin ALS-gerelateerde veranderingen zijn ingebouwd, en met geavanceerde analyses van menselijk hersenweefsel na overlijden. Daarnaast wordt een biobank gebruikt met bloed- en ruggenmergvochtstalen van ALS-patiënten.
Door deze uiteenlopende informatiebronnen te combineren — zoals gegevens over genactiviteit, eiwitten en ruimtelijke weefseldata — zoeken de onderzoekers naar stoffen die typisch zijn voor bepaalde celtypes of voor cellulaire processen die bij ALS verstoord raken.

Representatieve dwarsdoorsnede van het menselijke ruggenmerg geanalyseerd met Xenium-spatiale transcriptomics. Het niet-dissociatieve protocol behoudt de weefselarchitectuur en zeldzame celtypes, waaronder motorneuronen (zie ingezoomde inzet). De kleuringen worden weergegeven zoals aangegeven.
Wat wordt er ontwikkeld?
Het project zal een gevoelig biomarkerpanel ontwikkelen dat meerdere belangrijke ziektemechanismen in kaart brengt. Daarbij gaat het onder meer om problemen in het transport binnen zenuwcellen, verstoringen in het opruimen en verwerken van eiwitten (proteostase), ontstekingsprocessen in het zenuwstelsel en problemen in ondersteunende cellen zoals oligodendrocyten.
Dit biomarkerpanel kan bijdragen aan een snellere en nauwkeurigere diagnose van ALS. Daarnaast kan het helpen om patiënten onder te verdelen in beter herkenbare subgroepen en om op te volgen of een behandeling daadwerkelijk effect heeft.
Wie werkt eraan?
Door gebruik te maken van de gecombineerde expertise binnen het LEUCALS-consortium — variërend van klinische neurologie, neurobiologie en klinische biomarkerontwikkeling — brengt dit project de complementaire kennis samen van professoren Sandrine Da Cruz, Koen Poesen, Philip Van Damme en Ludo Van Den Bosch.
Deze geïntegreerde aanpak creëert een unieke opportuniteit om mechanistische inzichten doelgericht te vertalen naar klinisch toepasbare tools en zo de ontwikkeling van precisiegeneeskunde voor ALS te versnellen.
Bron: website KU Leuven – Groep Biomedische Wetenschappen

